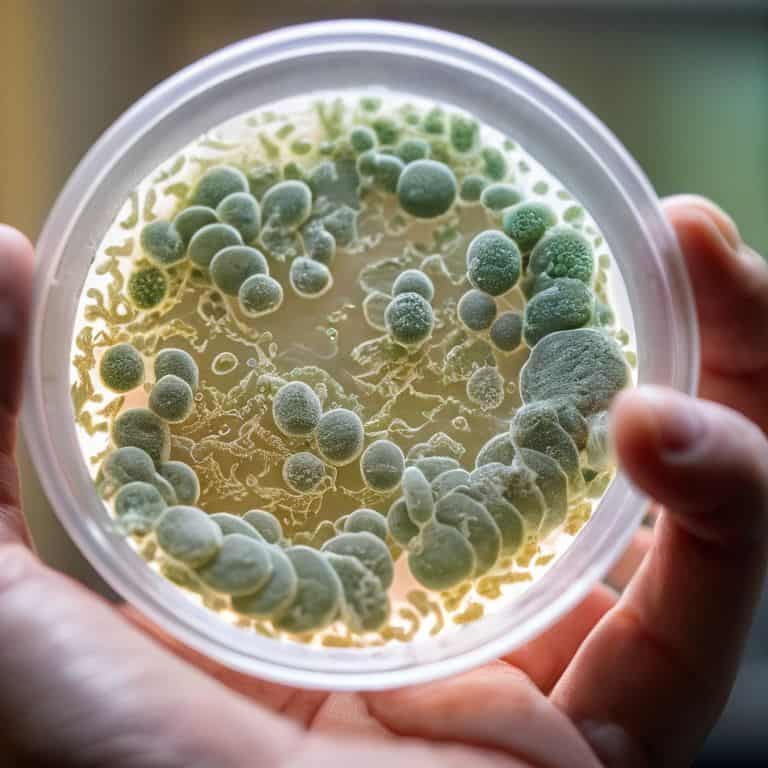

I still remember the day I stumbled upon a trendy wellness blog claiming that the gut-brain axis was the secret to unlocking ultimate happiness and health. As a neuroscientist, I was appalled by the oversimplification and lack of scientific evidence to support such a claim. It’s frustrating to see how the concept of the gut-brain axis has been hijacked by the wellness industry, turning it into a marketing buzzword. In reality, the relationship between our gut and brain is far more complex and nuanced.
As someone who’s spent years studying the effects of chronic stress on the brain, I’m committed to providing you with honest, evidence-based advice on how to harness the power of the gut-brain axis for your well-being. In this article, I’ll cut through the noise and share my personal insights on how to nurture a healthy gut-brain connection, without resorting to fancy supplements or expensive gimmicks. My goal is to empower you with practical, actionable strategies that are grounded in science, not speculation. By the end of this journey, you’ll have a deeper understanding of the gut-brain axis and how to make informed decisions about your health, free from the influence of pseudoscience and marketing fluff.
Table of Contents
Cracking the Gut Brain Axis

As I delve into the gut brain connection research, it’s striking to see how our microbiome plays a pivotal role in shaping our mental landscape. The influence of our microbiome on our mood is a complex interplay, with certain probiotic strains showing promise in alleviating symptoms of anxiety. I’ve found it fascinating to explore how dietary fiber can impact our mental clarity, and the potential consequences of neglecting this crucial aspect of our diet.
The concept of leaky gut syndrome symptoms is often shrouded in mystery, but it’s essential to understand the underlying mechanisms. When our gut lining becomes compromised, it can lead to a cascade of issues, including increased inflammation and oxidative stress. This, in turn, can have a profound impact on our mental health, exacerbating conditions like depression. As someone who’s passionate about psychobiotics for depression, I believe it’s crucial to explore the therapeutic potential of these microorganisms.
By examining the intricate relationships within our gut, we can begin to unravel the mysteries of our mental health. It’s not just about finding a quick fix or a miracle cure; it’s about cultivating a deeper understanding of the complex interplay between our microbiome, diet, and mental well-being. As we continue to uncover the secrets of the gut-brain connection, we may just discover that the key to mental clarity lies in the unlikeliest of places – our gut.
Gut Brain Connection Research Revealed
As I delve into the gut-brain axis, I’m reminded of the fascinating research that has shed light on this complex relationship. Studies have shown that the gut and brain are connected through the vagus nerve, allowing for bidirectional communication between the two. This has significant implications for our understanding of various neurological and gastrointestinal disorders.
Recent findings have highlighted the importance of microbiome balance in maintaining a healthy gut-brain connection. An imbalance of gut bacteria, also known as dysbiosis, has been linked to various conditions, including anxiety and depression. By understanding the intricacies of this relationship, we can begin to develop targeted therapies to promote a balanced microbiome and improve overall health.
Microbiome Influence on Mood Explained
The intricate relationship between our microbiome and mood is a fascinating area of study. Gut microbes play a significant role in producing neurotransmitters, such as serotonin and dopamine, which influence our mood and emotional state. Research has shown that an imbalance of these microbes, also known as dysbiosis, can lead to mood disorders like anxiety and depression.
A healthy microbiome is essential for maintaining a balanced mood. When our gut is populated with a diverse range of beneficial microbes, it can effectively regulate the production of neurotransmitters, leading to a more stable emotional state. This is an area where lifestyle changes, such as diet and exercise, can have a profound impact on our mental wellbeing.
Harnessing the Gut Brain Axis
To effectively harness the connection between our gut and brain, it’s essential to understand the role of probiotic strains for anxiety. Certain strains, such as Bifidobacterium and Lactobacillus, have been shown to have a positive impact on mental health by reducing symptoms of anxiety and depression. By incorporating these probiotics into our diet, either through supplements or fermented foods, we can promote a healthier gut microbiome.
The impact of dietary choices on our mental clarity cannot be overstated. Dietary fiber and mental clarity are closely linked, as a high-fiber diet promotes the growth of beneficial gut bacteria. This, in turn, supports the production of neurotransmitters that regulate mood and cognitive function. By making informed dietary choices, we can take the first step towards improving our mental health and reducing the risk of conditions like leaky gut syndrome symptoms.
By embracing a holistic approach to health, one that considers the intricate relationship between our gut and brain, we can unlock new avenues for managing mental health. Psychobiotics for depression are a promising area of research, offering a potential new tool in the fight against this debilitating condition. As we continue to explore the complexities of the gut-brain connection, it’s clear that a deeper understanding of this relationship holds the key to unlocking lasting wellness.
Dietary Fiber for Mental Clarity
As I hit the trails for a morning run, I often ponder the intricate relationship between diet and mental clarity. A key component of this connection is dietary fiber, which plays a crucial role in supporting the growth of beneficial gut bacteria.
Incorporating high-fiber foods into your diet can have a profound impact on your mental wellbeing, from reducing symptoms of anxiety to promoting a sense of calm and focus.
Probiotic Strains for Anxiety Relief
When it comes to probiotic strains for anxiety relief, I always look for evidence-based solutions. Certain strains like Bifidobacterium and Lactobacillus have shown promise in reducing symptoms of anxiety by producing neurotransmitters that calm the mind.
I recommend exploring probiotic supplements that contain multiple strains, as they can have a more significant impact on gut health and, subsequently, anxiety levels.
5 Evidence-Backed Tips to Optimize Your Gut-Brain Axis

- Focus on whole, unprocessed foods to promote a diverse gut microbiome, as research has shown that a varied diet rich in fruits, vegetables, and whole grains supports a healthy balance of gut bacteria
- Incorporate fermented foods like kimchi, sauerkraut, and kefir into your diet to boost probiotic intake, which has been linked to improved mood and cognitive function
- Stay hydrated by drinking plenty of water, as even mild dehydration can disrupt gut function and lead to symptoms like brain fog and anxiety
- Experiment with mindfulness practices like meditation and deep breathing to reduce stress, which can have a positive impact on the gut-brain axis by decreasing inflammation and promoting a healthy gut environment
- Consider consulting with a healthcare professional about supplementing with omega-3 fatty acids, particularly EPA and DHA, which have been shown to support gut health and reduce symptoms of depression and anxiety
Key Takeaways: Navigating the Gut-Brain Axis for Better Health
By understanding the intricate relationship between the gut and the brain, individuals can make informed decisions to support their mental and physical well-being, moving beyond mere awareness of the gut-brain axis to actionable strategies for health improvement.
Specific dietary adjustments, such as incorporating certain probiotic strains and increasing dietary fiber intake, can have a profound impact on mood regulation and mental clarity, offering a natural and evidence-based approach to managing anxiety and promoting cognitive function.
Cutting through the noise of wellness fads and pseudoscience, embracing an evidence-based approach to gut-brain health empowers individuals to take control of their health, making sustainable lifestyle choices that are grounded in scientific research rather than fleeting trends or unproven claims.
Unpacking the Truth
The gut-brain axis is not just a trendy buzzword – it’s a profound gateway to understanding how our bodies and minds are inextricably linked, and by embracing the science behind it, we can liberate ourselves from the grasp of anxiety, depression, and chronic stress.
Dr. Alistair Finch
Conclusion: Taking Control of Your Gut-Brain Axis
As we’ve explored the complex relationship between the gut and the brain, it’s clear that harnessing the gut-brain axis is key to unlocking overall health and wellness. From the latest research on the microbiome’s influence on mood to the practical applications of probiotic strains for anxiety relief and dietary fiber for mental clarity, the science is undeniable. By understanding the gut-brain connection and making informed choices about our diet and lifestyle, we can take the first steps towards reclaiming our health and wellbeing.
So, as you move forward, remember that every bite counts and small changes can add up. By embracing an evidence-based approach to wellness and ditching the fads, you’ll be empowered to make a real difference in your life. As someone who’s dedicated their career to translating complex science into actionable advice, I’m excited to see the positive impact you’ll have on your own health and the health of those around you.
Frequently Asked Questions
How can I determine if my gut health is impacting my mental well-being?
To determine if your gut health is impacting your mental well-being, pay attention to symptoms like bloating, abdominal pain, and changes in bowel habits alongside mood shifts. Keep a symptom journal to track correlations, and consider consulting a healthcare professional for guidance on gut health testing and personalized advice.
Are there any specific foods or nutrients that can help support a healthy gut-brain axis?
Let’s get specific – foods rich in polyphenols like berries, green tea, and dark chocolate can help support the gut-brain axis, while omega-3 fatty acids found in fatty fish and flaxseeds also play a key role. I’ll break down the science behind these nutrients in my next section.
Can an imbalance in the gut microbiome be a underlying cause of anxiety or depression?
Yes, research suggests that an imbalance in the gut microbiome, also known as dysbiosis, can contribute to anxiety and depression. Studies have shown that alterations in the gut microbiota can influence mood regulation, with certain bacterial strains producing neuroactive compounds that affect brain function.